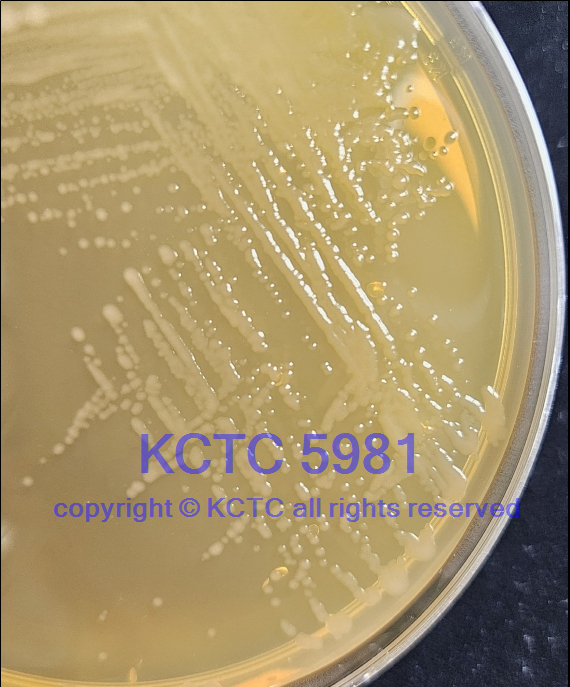

Blautia stercoris Park et al. 2012
Taxonomy in NCBI database: Bacteria; Firmicutes; Clostridia; Eubacteriales; Lachnospiraceae.
17204T <-- J.-W. Bae GAM6-1.
Accessioned in 2010.
=KCTC 5981.
Type strain [9041].
Medium: 675; Temperature: 37°C; Anaerobic.
open link in new window
Source: Human feces [9041].
Biochemistry/Physiology: [9041].
Fatty acid: [9041].
G+C (mol%): 35.6 (Tm, fluorimetric method) [9041].
Phylogeny: 16S rRNA gene (LC638721, HM626177) [9041].
NCBI Taxonomy ID: 871664.
Publication(s) using this strain [C12258]. Related information on delivery / use of the strainBiosafety level 1
Terms and conditions Not imposed
Export control (1) No
Distribution control in Japan (2) No
Genetically modified microorganism No
Technical information -
Additional information -
(1) in complying with the Foreign Exchange and Foreign Trade Control Law of Japan
(2) in complying with the Plant Protection Law of Japan
Delivery categoryDomestic B (Actively growing culture of a microbial strain that is not preserved as a dried culture / a microbial strain of which dried ampoules are not available)
Overseas B (Actively growing culture of a microbial strain that is not preserved as a dried culture / a microbial strain of which dried ampoules are not available)
Viability and purity assays of this product were performed at the time of production as part of quality control. The authenticity of the culture was confirmed by analyzing an appropriate gene sequence, e.g., the 16S rRNA gene for prokaryotes, the D1/D2 region of LSU rRNA gene, the ITS region of the nuclear rRNA operon, etc. for eukaryotes. The characteristics and/or functions of the strain appearing in the catalogue are based on information from the corresponding literature and JCM does not guarantee them.